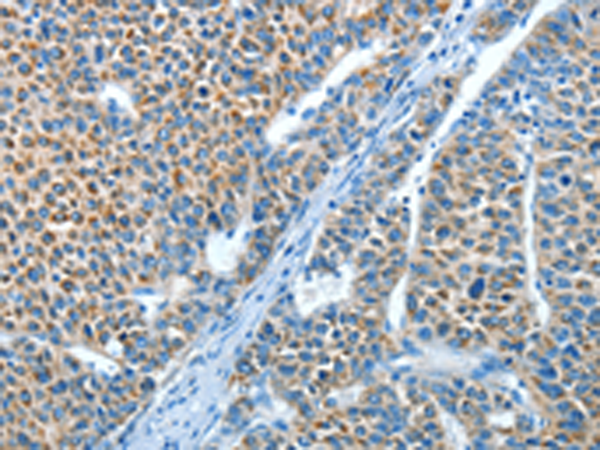
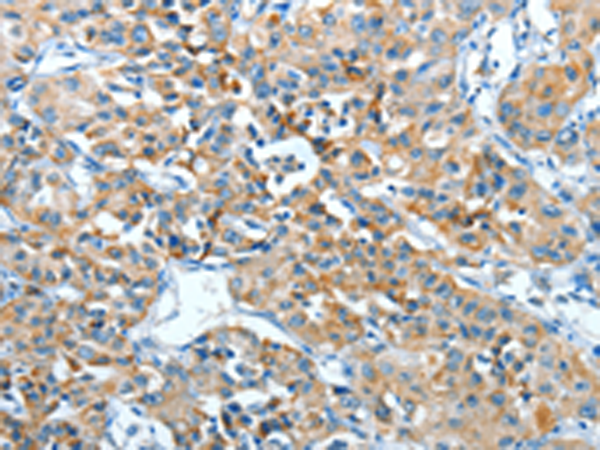
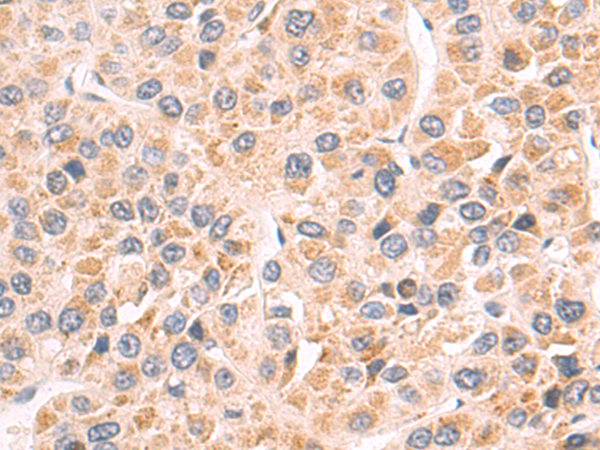

-
分类: 科研抗体货号: P11434别名: HOT; ADH8; HMFT2263应用: IHC反应种属: Human, Mouse, Rat
-
分类: 科研抗体货号: P11433别名: ADH2; HEL-S-117应用: WB,IHC反应种属: Human
-
分类: 科研抗体货号: P11449别名: ADRA1; ALPHA1BAR应用: WB,IHC反应种属: Human, Mouse, Rat
-
分类: 科研抗体货号: P11431别名: AC1应用: IHC反应种属: Human
-
分类: 科研抗体货号: P11448别名: STHE; HKPX1应用: WB,IHC反应种属: Human, Mouse, Rat
-
分类: 科研抗体货号: P11430别名: A2aR; RDC8; ADORA2应用: IHC反应种属: Human
-
分类: 科研抗体货号: P11447别名: ADRA1C; ADRA1L1; ALPHA1AAR应用: WB,IHC反应种属: Human, Mouse, Rat
-
分类: 科研抗体货号: P11429别名: RDC7应用: IHC反应种属: Human
-
分类: 科研抗体货号: P11446别名: GT8; CDG1P应用: IHC反应种属: Human, Mouse
-
分类: 科研抗体货号: P11427别名: ADAMTS16s应用: WB,IHC反应种属: Human, Mouse

鄂公网安备42018502007531号
鄂公网安备42018502007531号

